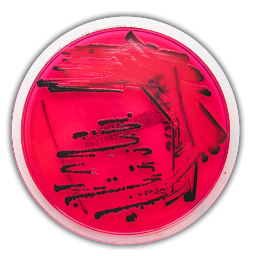
Sciencemethods's profile picture. Making hard research easier. Join us in creating the worlds best open source and peer reviewed science methodologies database. ^tm is @tommitchell ^sf is @sofaf

#sciencemethods search results
What better than ending the semester with cooking s’mores to test our solar oven design?#sciencemethods #lastdayofclasses @umeducation #PBL #ScienceEd




Great day for some local exploration! #sciencemethods #futurescienceteachers #swamplife @GeoSouthernCOE #placebasedlearning #scientistteachers



Prof. Kathryn Lilley speaks on the OOPS method at a #Proteomics meeting in Québec City. #massspectrometry #sciencemethods

Current and graduated doc students join forces in planning for a Science Methods Course in the spring. #scienceed #sciencemethods

Love that we can have class on the beach without even leaving campus. Drawing Venn diagrams in the sand. Classifying found objects. Learning to teach science. @TEPatUCSB @GGSEucsb #sciencemethods

With my activity at @MedaryMCL, students discussed where we find water and ice and discovered the impact of salt on ice and water. It was so awesome to see the students make predictions and inferences about the effects of the salt! #sciencemethods

Today I told my elementary teacher candidates that after I read their “getting to know you” assignment that the majority of them fear teaching science...I have one semester to turn that around! #sciencemethods #E328

Blast from the past. A few years ago Quat256 was the buzzword in my district. What now? #chemchat #sciencemethods @SecScienceKISD @KatyHSPrincipal @EllaMilton8

Elementary #sciencemethods students at @almacollege working through @ASTbigideas practice 4: Pressing for evidence-based explanations in the context of #LegoManInSpace #ambitiousscienceteaching @AmbScienceTeach

Helping the three billy goats get to the grassy side! 🐐😈 @lisaspencilbox #sciencemethods #latechteacher

We are Digging into the 5E’s in EDU 305 with a digital gallery exploration! #ScienceMethods #LessonPlanning @WPeaceU


What does your science education journey include? When you look up at the sky...What do you notice? What do you wonder? @WPeaceU #EDU305 #ScienceMethods #SharingTheJourney #ModelingPhenonmenon



Who wants to stay in one room all semester...not me! Cross campus collaboration is key. Thank you @IUSLib for investing in a “STEMtastic” future with our teacher candidates. #E328 #sciencemethods


When we all feel like super cool scientist in front of the class. The magic of disappearing water using diaper crystals! #E328 #sciencemethods
Helping the Billy Goats cross the bridge! @lisaspencilbox #sciencemethods #latechteacher #itriedmybest ❤️💙


When your EDU 305 Student makes your day! #8 #TeachingTeachers #ScienceMethods #PeaceUniversity #SaturdayGrading #Passion #WhyILoveToTeach @WPeaceU

See what real people can do if they don't have a worm-headed @SecKennedy in charge of #Healthcare? True #sciencemethods innovation. #ImpeachKennedyNow
It was a great start to the day with a mid-week lab in Conklin's class covering the Bohr atom and emission spectra. #GLBEC #ScienceMethods




Thanks to the Mid-Atlantic ASTE and SSMA Conferences for allowing me to present my experiences with pico balloons! #sciencemethods #picoballoons #STEMEducation


🔗 This structure ensures researchers can find the details they need, reducing confusion and improving the reproducibility of studies. A clear supplement = more impact. #TransparencyInResearch #ScienceMethods x.com/MMLS_journal/s… 10/13
🌟📑 #SuperSupplements: The (Almost) Thankless Work of a Supplement 📱✨ Today, we explore the impact of social media on the accessibility and visibility of academic supplements, inspired by a viral post highlighting the challenges researchers face. Join us as we explore... 1/10
We've been supercharging our learning experience with @padlet? 🚀 From brainstorming to collaborating on assignments, Padlet has become our ultimate academic sidekick! Our @latechcil #sciencemethods course completed an anchoring phenomenon routine with slinkies and Padlet.
#Bias from knowledge not the same as bias from ignorance #ScienceMethods have been developed to reduce bias, and to share knowledge. #SharedFacts
Loved making Oobkeck and discussing Non-Newtonian liquids with my @UHClearLake #ScienceMethods students! They had so much fun making connections with viscosity, rheology, and volcanology!



Li et al., "PhenoWell®—A novel screening system for soil-grown plants" Plant-Environment Interactions (2023). doi.org/10.1002/pei3.1… @wileyplantsci @wileyinresearch @WileyEcolEvol #Sciencemethods #Ecology #Plantsci #Scopus

Li et al., "PhenoWell®—A novel screening system for soil-grown plants" Plant-Environment Interactions (2023). doi.org/10.1002/pei3.1… @wileyplantsci @wileyinresearch @WileyEcolEvol #Sciencemethods #Ecology #Plantsci #Scopus

Li et al., "PhenoWell®—A novel screening system for soil-grown plants" Plant-Environment Interactions (2023). doi.org/10.1002/pei3.1… @wileyplantsci @wileyinresearch @WileyEcolEvol #Sciencemethods #Ecology #Plantsci #Scopus

#Bias from knowledge not the same as bias from ignorance #ScienceMethods have been developed to reduce bias, and to share knowledge. #SharedFacts
#Bias from knowledge not the same as bias from ignorance #ScienceMethods have been developed to reduce bias, and to share knowledge. #SharedFacts
My #sciencemethods students had ChatGPT create an assessment aligned with their lesson plan objective…they were amazed! Then I had them “level-up” the assessment to make it better…I was amazed😍 #edchat #highereducation #k12 #ai #edtech
Excited about this week’s #sciencemethods lesson where we will “level up” a standard aligned assessment created by ChatGPT! #ai #edchat #highereducation #k12 #latechteacher #xr
#Bias from knowledge not the same as bias from ignorance #ScienceMethods have been developed to reduce bias, and to share knowledge. #SharedFacts
#Bias from knowledge not the same as bias from ignorance #ScienceMethods have been developed to reduce bias, and to share knowledge. #SharedFacts
What do you notice? What do you wonder? How do we channel that curiosity into productive discourse in science? Another great day in elem. science methods with really thoughtful future teachers! #noticewonder #sciencemethods @UWyoCoED


#Bias from knowledge not the same as bias from ignorance #ScienceMethods have been developed to reduce bias, and to share knowledge. #SharedFacts
Elementary #sciencemethods students at @almacollege working through @ASTbigideas practice 4: Pressing for evidence-based explanations in the context of #LegoManInSpace #ambitiousscienceteaching @AmbScienceTeach

To mimic a larval invasion, the #InvasionPressureExp team "doses" an area with thousands of oysters #InvasiveSpecies #ScienceMethods

@edhdbgsu Future Teachers Human Scatterplot #doingscienceprobe #formativeassessment #sciencemethods @CTSKeeley


Very impressed by classmates presentation on how bubbler acts as insulation for whales. #stem #sciencemethods #molloylife


Today my fourth graders learned how to make their clay float with the power of buoyancy! #sciencemethods #scienceisFUN #sinkorfloat




Love that we can have class on the beach without even leaving campus. Drawing Venn diagrams in the sand. Classifying found objects. Learning to teach science. @TEPatUCSB @GGSEucsb #sciencemethods

Making DNA models using candies. Great activity for Kinesthestic Learners! #sciencemethods #DNA #molloylife

Big kids aren't so bad! Loved working with @gracecollege students exploring Bee-Bots and coding! Thanks @NicoleBaird1 🐝 #sciencemethods

Current and graduated doc students join forces in planning for a Science Methods Course in the spring. #scienceed #sciencemethods

Can we survive in a world that is solely powered by renewable resources? STAY TUNED! #sciencemethods #energy #windfarms

Something went wrong.
Something went wrong.
United States Trends
- 1. Veterans Day 417K posts
- 2. Tangle and Whisper 4,324 posts
- 3. Woody 16.5K posts
- 4. Jeezy 1,534 posts
- 5. State of Play 29.6K posts
- 6. Toy Story 5 23.3K posts
- 7. AiAi 12K posts
- 8. Luka 87.2K posts
- 9. #ShootingStar N/A
- 10. Gambit 48.3K posts
- 11. Nico 149K posts
- 12. Wanda 32.3K posts
- 13. NiGHTS 59.1K posts
- 14. Tish 6,692 posts
- 15. #SonicRacingCrossWorlds 3,048 posts
- 16. Errtime N/A
- 17. Marvel Tokon 2,816 posts
- 18. Nightreign DLC 13.9K posts
- 19. Travis Hunter 4,509 posts
- 20. SBMM 1,851 posts